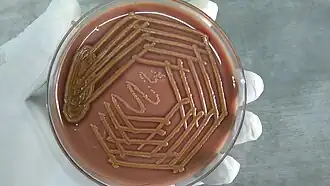

Sphingobacteriaceae
| Sphingobacteriaceae | ||||||||||
|---|---|---|---|---|---|---|---|---|---|---|
Sphingobacterium mizutii | ||||||||||
| Systematik | ||||||||||
| ||||||||||
| Wissenschaftlicher Name | ||||||||||
| Sphingobacteriaceae | ||||||||||
| P. L. Steyn et al. 1998 |
Die Sphingobacteriaceae sind eine Familie von Bakterien. Die Typusgattung ist Sphingobacterium. Sie zählen zu der Abteilung Bacteroidota.
Merkmale
Der Gram-Test ist negativ. Es handelt sich um stäbchenförmige Bakterien, die Größe liegt z. B. von Pedobacter und Sphingobacterium im Bereich von 0,3 – 0,6 × 0,5 – 0,6 μm.[1] Flagellen sind nicht vorhanden, Bewegung kann aber bei einigen Arten gleitend erfolgen. Die Kolonien sind meist nach einigen Tagen gelblich gefärbt. Der Katalase- und Oxidase-Test fällt positiv aus. Auch der Phosphatasetest ist positiv. Sie sind aerob und chemo-organotroph.

Ein wichtiges Merkmal und namensgebend ist die Bildung von Sphingolipiden, und zwar Sphingophospholipide und Ceramide. Diese Art von Lipiden kommen nur bei wenigen Bakteriengruppen vor. Arten die Sphingolipide enthalten zählen z. B. zu der Familie Sphingomonadaceae, zu den Proteobacteria gestellt, und einige Arten der Bacteroides, die wie auch die Sphingobacteria zu den Bacteroidetes zählen.[2] Das Vorkommen dieser Lipide dient auch als wichtiges Unterscheidungsmerkmal zu den Flavobacteriaceae. Ein weiteres wichtiges Merkmal zur Unterscheidung von den Flavobakterien ist das Menachinon 7.
Vorkommen
Sie wurden u. a. im Boden, Kompost und Süßwasser gefunden. Einige sind freilebend, andere sind saprophytisch. Verschiedene Arten sind weltweit und in verschiedenen klimatischen Bedingungen verbreitet, so wurden z. B. Arten von Pedobacter in den Tropen und kalten Regionen wie im Himalaya, Alpen und in Island gefunden. Psychrotolerante, also starke Kälte tolerierende Pedobacter- Stämme wurden aus Böden und verwesenden Flechten aus Wäldern in der finnischen Arktis isoliert. Die gefundenen Stämme waren nah mit den Arten Pedobacter cryoconitis und Pedobacter himalayensis verwandt.[3]
Systematik
Sphingobacterium spiritivorum und Sphingobacterium multivorum wurden anfangs in der Gattung Flavobacterium geführt. 1983 wurden sie von Eiko Yabuuchi zu der neu eingeführten Gattung Sphingobacterium gestellt, u. a. aufgrund der enthaltenen Sphingolipide. Die Familie Sphingobacteriaceae wurde von Steyn et al. 1998 eingeführt. Es folgt eine Liste einiger Gattungen:[4]
- Anseongella Siddiqi et al. 2016
- Arcticibacter Prasad et al. 2013
- Mucilaginibacter Pankratov et al. 2007
- Nubsella Asker et al. 2008
- Olivibacter Ntougias et al. 2007
- Parapedobacter Kim et al. 2007
- Pedobacter Steyn et al. 1998
- Solitalea Weon et al. 2009
- Sphingobacterium Yabuuchi et al. 1983
Der Gattungsname Pseudosphingobacterium Vaz-Moreira et al. 2007 ist ein Synonym für die Gattung Olivibacter Ntougias et al. 2007
Einzelnachweise
- ↑ Noel R. Krieg u. a. (Hrsg.): Bergey’s Manual of Systematic Bacteriology. 2. Auflage, Band 4: The Bacteroidetes, Spirochaetes, Tenericutes (Mollicutes), Acidobacteria, Fibrobacteres, Fusobacteria, Dictyoglomi, Gemmatimonadetes, Lentisphaerae, Verrucomicrobia, Chlamydiae, and Planctomycetes. Springer, New York 2010, ISBN 978-0-387-68572-4, S. 457–467 (online).
- ↑ H. N. Shah, M. D. Collins: Genus Bacteroides. A chemotaxonomical perspective. In: Journal of Applied Bacteriology. Band 55, 1983, S. 403–416.
- ↑ Robert V. Miller und Lyle G. Whyte: Polar Microbiology. Life in a Deep Freeze. 29 December 2011, ASM Press. ISBN 978-1-55581-718-3. S. 19
- ↑ Systematik nach J. P. Euzéby: List of Prokaryotic names with Standing in Nomenclature (LPSN) (Stand: 4. Juni 2020)
Literatur
- Noel R. Krieg u. a. (Hrsg.): Bergey’s Manual of Systematic Bacteriology. 2. Auflage, Band 4: The Bacteroidetes, Spirochaetes, Tenericutes (Mollicutes), Acidobacteria, Fibrobacteres, Fusobacteria, Dictyoglomi, Gemmatimonadetes, Lentisphaerae, Verrucomicrobia, Chlamydiae, and Planctomycetes. Springer, New York 2010, ISBN 978-0-387-68572-4, S. 331–351 (online).